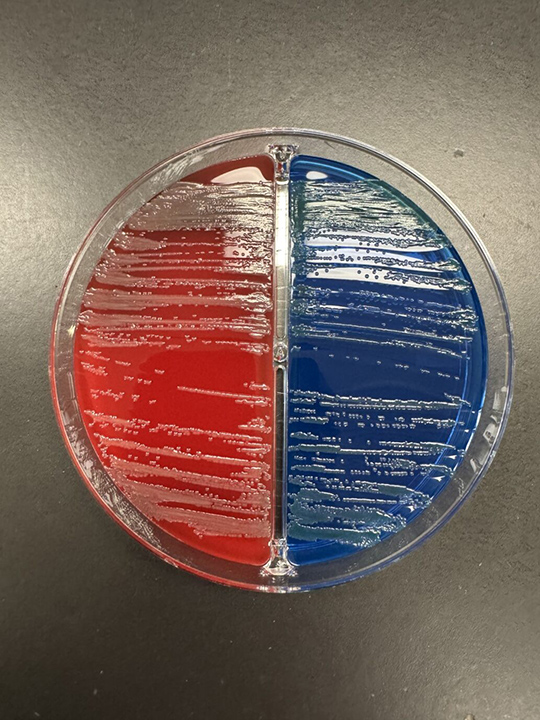
microbiology round - 亀田総合病院 感染症内科

mape おまとめP. Bacteria (TC)【51】【41】【40】 ビカクシダ バクテリア P. willinckii 'Bacteria' TC【816
(3006件)
Pontaパス特典
サンキュー配送
11156円(税込)
112ポイント(1%)
Pontaパス会員ならさらに+1%ポイント還元!
送料
(
)
3002
配送情報
お届け予定日:2026.04.11 10:58までにお届け
※一部地域・離島につきましては、表示のお届け予定日期間内にお届けできない場合があります。
ロットナンバー
78872100242
お買い物の前にチェック!

Pontaパス会員なら
ポイント+1%
ポイント+1%
商品説明





ご覧いただきありがとうございます。【発送について】冬季の発送は メルカリ便を予定しております。第四種郵便をご希望の場合は500円のお値引きを行なっておりますので購入前にお申し付けください。※ご購入後は変更出来ませんので必ず事前にお申し付けください。こちらの商品は 台湾のビカクシダ専門店より直接輸入した正規品ですので、安心してお迎えいただけます。ネームタグに関してはNyoqi Plantsのタグを同封させていただきます。育成の様子や植物の日常などはInstagram(ID: nyoqi_)でも発信しています。もし気になることがありましたら、そちらもあわせてご覧いただけると嬉しいです。誠実で丁寧なお取引を心がけております。植物は生き物であるため、プロフィールに記載しております注意点をご理解のうえご検討ください。『冬季の梱包方法について』冬の寒さが本格的になってきたため、“冬仕様の特別梱包” に変更いたしました。最後の写真をご覧下さい。植物が寒さでダメージを受けないよう、できる限り万全の状態で発送いたします。東北・北海道・寒冷地へお住まいの方へ最低気温が0℃を大きく下回る地域では、追加の対策が必要になる場合があります。そのため、ご購入前に一度ご連絡いただけると助かります。【同梱について】・同梱をご希望の場合は【まとめて取引】をご利用ください。点数により下記のサービスを行います!!・2点おまとめ購入の場合、¥500引き・3点おまとめ購入の場合、¥1000引きおまとめ購入をご検討よろしくお願い致します。
| カテゴリー: | フラワー・ガーデニング>>>観葉植物>>>ビカクシダ |
|---|---|
| 商品の状態: | 目立った傷や汚れなし","細かな使用感・傷・汚れはあるが、目立たない |
| 配送料の負担: | 送料込み(出品者負担) |
| 配送の方法: | 佐川急便/日本郵便 |
| 発送元の地域: | 福岡県 |
| 発送までの日数: | 1~2日で発送 |
レビュー
商品の評価:




 4.6点(3006件)
4.6点(3006件)
- ワンダ6616
- 観葉植物の水やりが本当に苦手でしたが、これはめちゃめちゃ水やりのタイミングがわかりやすくて助かります! レフィルも2本ついていてコスパも最強です。
- BW0909
- 迅速な対応ですぐに商品がとどきました。 ありがとうございました。
- kounj
- 北欧調の植木鉢カバーを探していました。 アジアンティストですが、強すぎないですし、お手頃価格だったので良かったです。
- apple green2469
- 観葉植物を吊るすのに購入しました。 とてもおしゃれなチェーンでした。
- すずんこ888
- 商品画像通りの素敵なお品でした。 合わせようと購入していた植物とも相性バッチリ。 これからの経年変化が楽しみです。
- ravu2sei
- トイレタンクの飾りとして購入しました。Mサイズでちょうど良く思いました。Sだと穴に入ってしまうかもしれません。水に濡れると色が変わり楽しめます。石の粉?が付いているので使用前に石を洗った方がタンクが汚れなくていいと思います。
- キング9648
- マクラメハンギング色々探しましたが、最安値だと思います 現品も安っぽく無くしっかりとしていました 鉢もセットかとというレビューもありましたが値段をみれば一目瞭然だと思います
- くう1011
- 梱包も丁寧で、ほとんど満足です。 ただ触ってると粉がポロポロ落ちるので、ちょっと掃除が必要かなぁ? だけどデザインはとても可愛いし、軽いので重さを気にせず何処にでもかけられそうです。
- 梅きよ
- とても良いモノが届きました♪ また利用させて頂きます♪
- labo07
- 日照不足が原因と思われる観葉植物達のために購入しました。早速、一番元気の無かったヒポエステスに一晩当ててみたところ…明らかに元気になり、小さな新葉が出ていました!オシャレだし効果も期待できるし、オススメです。
- shin-teioh
- 私は趣味で斑入りのモンステラとマドカズラを育ています。比較的成長スピードが遅い植物です。今までピクリともしなかったのに商品を使用して数日で著しい成長を見せてくれました。正直ビックリしました!ただ商品のスイッチに不具合がありレビュー投稿させてもらいました。安かったし使えないことはなかったのでこのまま使用し続ける事しました。レビュー投稿後間もなくショップから謝罪のメールがきてその後新しい商品を送って頂きました。商品効果、そしてショップの方々の迅速な対応、最高です!
- hitti4024
- とても気に入ってます。 そだつかは今からですがとても楽しみです。 明るすぎないのでとてもかわいらしいです。
- kiteretu5
- 5V/2.4Aのアダプターがありませんでしたので仮設置しただけで、テストとしてライト点灯試験しましたが 大変扱いやすく植物の育成にいいように思います。 ただ1点気になったのですが40Wで5Vでしたら8A流れるので8A以上いるのではないのでしょうか。 安全面という点で大丈夫なのかが気になりましたので☆4個とさせて頂きました。
- かーみ102
- 水耕栽培を初めてやり始めました。 カーテン越しの光しか入らないので、使っています。初めてなので、育成具合がどうなのか、わからないのですが、今のところ順調に育っています。 上手くいけば、又、もう一つ買いたいと思います。
- タツカメ
- バフ(12)はミニチュアフードで揚げ物を作る時の衣の役割によさそうと思いました。
- yasu83226
- すぐ枯らすくせに、観葉植物が好きでまた買ってしまう私。 水やりのポイントがよくわからず、困っていました。土の表面が乾いたら、とか聞くものの、いまいち自信が持てず...。そんな中、たまたま情報誌を読んでいて出会った商品。 今現在、4本持っていますが、とても管理しやすくなりました。 それぞれ土の種類も、木の種類も、もちろん置いている場所も違うので、お知らせのペースが違いますし、見ただけで水のあげどきがわかるので、私のように自信のない方にはよい商品だと思います^^
すべて見る
お店の情報
7,367
連絡・応対
4.3
配送スピード
4.3
梱包
4.3